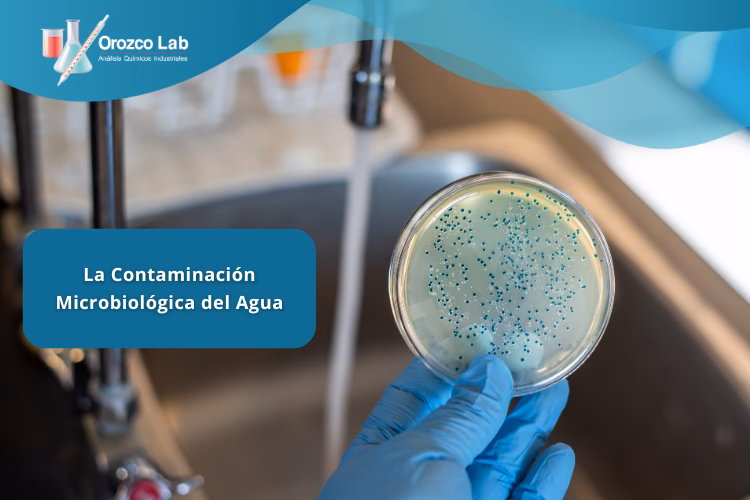
¿Cuáles son los aspectos químicos del agua?

21/06/2001
El agua es el recurso más preciado de nuestro planeta, el pilar fundamental sobre el que se sustenta toda forma de vida. Sin embargo, este recurso vital está bajo una amenaza constante y creciente: la contaminación. A menudo pensamos en la contaminación del agua como un problema lejano, algo que afecta a ríos en países remotos o a océanos llenos de plástico. La realidad es mucho más cercana y peligrosa. Desde el agua que bebemos hasta los ríos que alimentan nuestros campos, las consecuencias de la contaminación hídrica son devastadoras y multifacéticas, afectando nuestra salud, el equilibrio de los ecosistemas y la estabilidad de nuestra economía de formas que apenas comenzamos a comprender.
El Doble Filo de la Contaminación: Microbiológica y Química
Para entender la magnitud del problema, es crucial diferenciar entre los dos principales tipos de contaminación del agua. Aunque a menudo se solapan, sus orígenes y efectos son distintos, pero igualmente peligrosos.
1. Contaminación Microbiológica: La Amenaza Invisible
Esta es quizás la forma más antigua y directa de contaminación del agua. Se refiere a la presencia de microorganismos patógenos como bacterias, virus, protozoos y otros parásitos. Estos agentes llegan a las fuentes de agua principalmente a través de vertidos de aguas residuales sin tratar, escorrentía agrícola con desechos de ganado y sistemas de saneamiento deficientes.
Un punto crítico, y a menudo subestimado, ocurre durante el mantenimiento de las redes de distribución. El tendido de nuevas tuberías o reparaciones realizadas sin las mínimas medidas de seguridad pueden introducir una carga masiva de contaminantes directamente en el sistema que lleva el agua a nuestros hogares. En épocas de lluvias intensas o inundaciones, la contaminación de las fuentes de agua se dispara, produciendo variaciones bruscas en la calidad microbiológica. Esto puede llevar a aumentos repentinos en la concentración de bacterias como Escherichia coli o Salmonella, causantes de graves enfermedades gastrointestinales, cólera, fiebre tifoidea y disentería. Para las poblaciones más vulnerables, como niños y ancianos, una simple infección transmitida por el agua puede ser mortal.
2. Contaminación Química: El Veneno Lento
Esta categoría abarca una vasta gama de sustancias tóxicas que se disuelven o mezclan con el agua. A diferencia de los patógenos, muchos de estos contaminantes son inodoros, incoloros e insípidos, lo que los hace aún más peligrosos. Sus fuentes son principalmente industriales, agrícolas y domésticas.
- Metales Pesados: Sustancias como el mercurio, plomo, cadmio y arsénico, provenientes de la minería, vertidos industriales y tuberías antiguas, son extremadamente tóxicas. La exposición a metales pesados puede causar daños neurológicos irreversibles, problemas renales y diversos tipos de cáncer.
- Pesticidas y Fertilizantes: El uso extensivo en la agricultura moderna provoca que estos químicos se filtren hacia las aguas subterráneas y fluyan hacia ríos y lagos. Los nitratos de los fertilizantes son especialmente peligrosos para los bebés (pueden causar metahemoglobinemia o "síndrome del bebé azul") y contribuyen a la degradación masiva de los ecosistemas acuáticos.
- Residuos Industriales: Solventes, aceites, dioxinas y una infinidad de compuestos químicos son arrojados, a menudo ilegalmente, a las fuentes de agua. Muchos de estos son disruptores endocrinos, afectando el sistema hormonal de humanos y animales.
- Microplásticos: Pequeñas partículas de plástico provenientes de la degradación de residuos más grandes y de productos de cuidado personal. Su impacto a largo plazo en la salud humana todavía se está investigando, pero ya se sabe que actúan como esponjas para otras toxinas y se han encontrado en casi todos los rincones del planeta, desde el agua embotellada hasta la sal de mesa.
Tabla Comparativa de Tipos de Contaminación Hídrica
| Característica | Contaminación Microbiológica | Contaminación Química |
|---|---|---|
| Contaminantes Principales | Bacterias, virus, protozoos, parásitos. | Metales pesados, pesticidas, nitratos, microplásticos, fármacos. |
| Fuentes Comunes | Aguas residuales, desechos de ganado, sistemas de saneamiento deficientes. | Vertidos industriales, escorrentía agrícola, minería, residuos domésticos. |
| Efectos en la Salud Humana | Enfermedades agudas e infecciosas (cólera, tifoidea, gastroenteritis). | Enfermedades crónicas, cáncer, problemas neurológicos, disrupción hormonal. |
| Detección | Análisis microbiológicos específicos. | Análisis fisicoquímicos complejos. A menudo invisible, inodora e insípida. |
Impacto en los Ecosistemas: La Muerte Silenciosa de Nuestros Ríos y Mares
Las consecuencias de la contaminación del agua no se limitan a la salud humana. Los ecosistemas acuáticos son las primeras y más grandes víctimas. Un cuerpo de agua contaminado es un ecosistema moribundo.
El fenómeno más conocido es la Eutrofización. Ocurre cuando un exceso de nutrientes, principalmente nitrógeno y fósforo de los fertilizantes y aguas residuales, llega a un lago o río. Esto provoca una explosión de algas en la superficie que bloquean la luz solar, impidiendo que las plantas acuáticas del fondo realicen la fotosíntesis. Cuando estas algas mueren, su descomposición por parte de bacterias consume enormes cantidades de oxígeno disuelto en el agua. Esta falta de oxígeno crea "zonas muertas" donde peces y otros organismos acuáticos mueren masivamente por asfixia.

Además, la contaminación química provoca efectos devastadores a través de la bioacumulación. Las toxinas como el mercurio son absorbidas por organismos pequeños. A medida que estos son comidos por otros más grandes, la concentración de la toxina aumenta en cada nivel de la cadena alimentaria. Al final, depredadores como los grandes peces, las aves marinas y los propios seres humanos pueden acumular niveles letales de estas sustancias, aunque la concentración en el agua fuera inicialmente baja. Esto conduce a la pérdida de biodiversidad, la extinción de especies y el colapso de ecosistemas enteros que han tardado milenios en formarse.
Preguntas Frecuentes (FAQ)
¿Puedo saber si el agua está contaminada por su color, olor o sabor?
No siempre. Si bien un color turbio, un olor desagradable o un sabor extraño son claros indicios de contaminación, muchos de los contaminantes químicos más peligrosos (como el arsénico o el plomo) y microorganismos no alteran las propiedades organolépticas del agua. La única forma segura de saberlo es mediante un análisis de laboratorio.
¿Es suficiente hervir el agua para que sea segura?
Hervir el agua es un método muy eficaz para eliminar la contaminación microbiológica (bacterias, virus y parásitos). Sin embargo, no elimina los contaminantes químicos. De hecho, al hervir el agua, parte de esta se evapora, lo que puede aumentar la concentración de metales pesados o nitratos, haciéndola aún más peligrosa si está químicamente contaminada.
¿Qué puedo hacer yo para reducir la contaminación del agua?
Aunque el problema requiere soluciones a gran escala, las acciones individuales son fundamentales. Nunca arrojes aceites, pinturas, disolventes o medicamentos por el desagüe. Reduce el uso de pesticidas y fertilizantes químicos en tu jardín. Opta por productos de limpieza ecológicos. Y, sobre todo, reduce tu consumo general y desecha tus residuos correctamente para evitar que acaben en nuestras fuentes de agua.
Conclusión: Una Responsabilidad Compartida
Las consecuencias de la contaminación del agua son una cascada de efectos negativos que nos afectan a todos. Desde las enfermedades que nos debilitan hasta los ecosistemas que se derrumban y las economías que se resienten por los costes de tratamiento y la pérdida de recursos. Proteger la calidad de nuestras fuentes de agua no es una opción, es una necesidad imperativa para nuestra supervivencia y la del planeta. Requiere un esfuerzo coordinado de gobiernos, industrias y, fundamentalmente, de cada uno de nosotros como ciudadanos conscientes del valor incalculable de cada gota de agua limpia.
Si quieres conocer otros artículos parecidos a Impacto de la Contaminación Hídrica puedes visitar la categoría Ecología.

